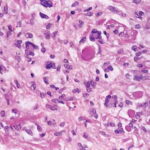

Dermatofibroma =الورم الليفي(الليفوم) الجلدي
|
Dermatofibroma
The overlying epidermis is usually acanthotic. Pseudoepitheliomatous hyperplasia and a basaloid proliferation may be noted. The hyperplasia may be caused by the action of fibroblasts on epidermal keratinocytes.23 Basal cell carcinomas occurring upon a dermatofibroma have been reported. Increased pigment may be seen, which may be iron or melanin. Most lesions display a grenz zone of normal papillary dermis overlying the tumor.
The subcutis typically is preserved, but if involved (especially when a storiform [cartwheel] pattern is observed), be alert to the possibility of the lesion being a dermatofibrosarcoma protuberans (DFSP).
One clinicopathologic classification scheme31 describes the following 4 categories of dermatofibroma: (1) those with architectural peculiarities, such as deep penetrating, atrophic, giant, aneurysmal (angiomatoid), hemangiopericytomalike, palisading, or ossifying variants; (2) cellular/stromal dermatofibromas, such as clear cell, granular cell, myofibroblastic, sclerotic, monster cell, atypical (pseudosarcomatous), elusive (hemosiderotic), cholesterotic (lipidized), and myxoid variants; (3) dermatofibromas with architectural and cellular/stromal changes in homogeneous arrangement, including epithelioid cell, cellular benign, smooth muscle proliferative, basal cell carcinoma–like, pseudolymphomatous, multinucleate cell angiohistiocytoma, cellular neurothekeoma, plexiform fibrohistiocytic tumor, plexiform xanthoma, and plexiform xanthomatous tumor subtypes; and (4) a complex, composite or combined dermatofibroma category with 2 or more architectural and cellular/stromal patterns in a single lesion. Of the variants listed above, keep in mind that the uncommon sclerotic fibromalike dermatofibroma should be differentiated from sclerotic fibroma. A 2005 study32 showed 7 of 7 of the former lesions to be negative for CD34 and CD99, while 3 of 3 solitary fibromas were positive for CD34 and CD99. For comparison, 14 of 14 "common-type" dermatofibromas in this study were negative for CD34, while 4 demonstrated positivity with CD99. In one study, CD10 was positive in 11 of 11 dermatofibromas and only positive in 1 of 7 epithelioid dermatofibromas, so it was postulated that epithelioid dermatofibroma may be a distinct entity.33 Lichenoid dermatofibroma, ulcerated dermatofibroma, erosive dermatofibroma, diffuse eosinophilic infiltrate dermatofibroma, dermatofibroma accompanied by perforating dermatosis, dermatofibroma with overlying sebaceous hyperplasia, dermatofibroma with intracytoplasmic globules,34 , signet-ring cell dermatofibroma,35 and amyloid light chain deposition36 have also been reported. A case of an apocrine gland cyst with a hemosiderotic dermatofibroma was termed an apocrine hemosiderotic dermatofibroma.37 Induction of adnexal structures by dermatofibroma is quite common and may mimic overlying basal cell carcinoma.38 A 2005 series39 reported the uncommon occurrence of dermatofibroma and melanocytic lesions in the same biopsy specimen. Four of 14 specimens showed the 2 processes to seemingly merge imperceptibly. The lesions included junctional, dermal, and compound nevi as well as a single case of melanoma in situ. Knowledge of this relationship can help prevent rendering the wrong diagnosis and is facilitated by the use of immunohistochemistry, with the melanocytic lesions showing S-100 and Mart-1 positivity with FXIIIa negativity and the dermatofibroma showing S-100 and Mart-1 negativity and FXIIIa positivity. A subsequent case report40 documenting an invasive melanoma occurring in association with a dermatofibroma underscores the role of these immunohistochemical stains. INI-1, present in 100% of dermatofibroma and 13% of epithelioid sarcoma, can help distinguish between these 2 lesions.41 |